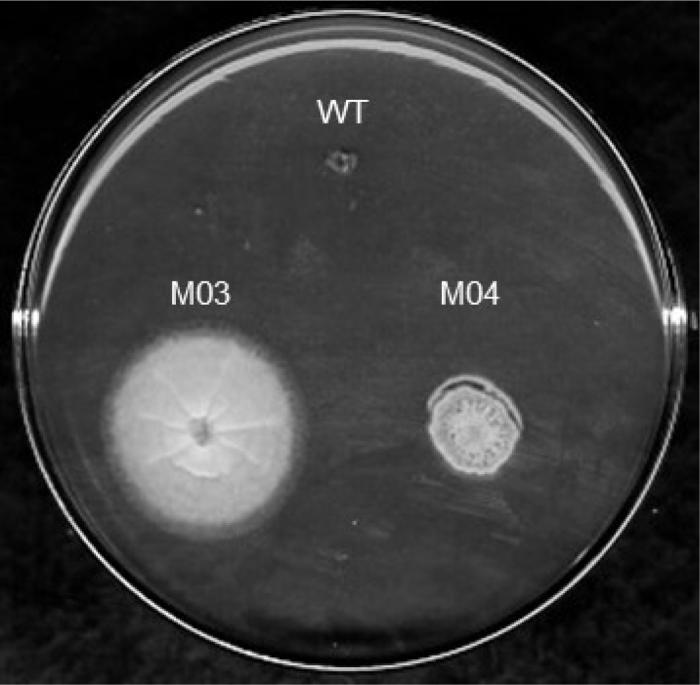
Fig. 1

Abstract
Expression of pectinolytic genes is regulated by catabolic repression limiting the production of pectin lyase (PL) if the natural inducer, pectin, is missing from the growth medium. Here, we report the isolation of Penicillium griseoroseum mutants resistant to 2-deoxy-d-glucose (DG) that show resistance to catabolite repression and overproduce PL. Three spontaneous and nine UV-induced mutants were obtained. Some mutants produced sectors (segments morphologically different) that were also studied. The mutants were analyzed for pectinases production on pectinase-agar plates and five mutants and two sectors showing larger clearing zones than the wild type were selected for quantitative assay. Although PL production higher than the wild type has been found, phenotype instability was observed for most of the mutants and, after transfers to nonselective medium, the DG resistance was no longer present. Only mutants M03 and M04 were stable maintaining the DG-resistance phenotype. When growing for 120 h in liquid medium containing glucose with or without pectin, both mutants showed higher PL production. In the presence of glucose as sole carbon source, the mutant M03 produced 7.8-fold more PL than the wild type. Due its phenotypic stability and PL overproduction, the mutant M03 presents potential for industrial applications.
Keywords: 2-Deoxy-d-glucose, Ultraviolet mutagenesis, Pectinolytic complex, Spontaneous mutant
Introduction
The Penicillium griseoroseum strain, isolated in Viçosa/MG (Brazil), is a good producer of pectin lyase (PL).1 That enzyme is part of the pectinolytic complex that catalyzes the degradation of pectic polysaccharides found in the plant cell wall and plays an important role in several industrial applications.2 PL is an important enzyme because it is the only known pectinase capable of degrading highly esterified pectin without the prior action of other enzymes.3, 4
Our group has studied several aspects of the P. griseoroseum physiology and genetics in order to search for strains over-producing PL for industrial application. For instance, two genes, plg1 and plg2, coding for pectin lyase in P. griseoroseum have been isolated.5 Pectin induces the plg1 expression and, in the absence of pectin, sucrose supplemented with yeast extract induced plg1 but not plg2 that showed basal levels of expression.6 The plg1 gene is repressed by glucose and other simple sugars, which is consequence of the catabolic repression.6 That mechanism inhibits the synthesis of enzymes required for the utilization of alternative carbon sources usually via repression of gene expression by CreA-like proteins.7 cAMP is involved in the PL production by P. griseoroseum8 and the plg1 expression is dependent of the cAMP transduction signal.6 The plg1 gene was used, after the development of a homologous transformation system,9 to obtain recombinant P. griseoroseum strains producing high levels of PL.10, 11 Besides that, we have used protoplast fusion between P. griseoroseum and Penicillium expansum to obtain increased PL production.12
Another approach to increase the production of pectinolytic enzymes in fungal species is the isolation of mutants.13 In that case, if a selection pressure is present, phenotypes of interest can be more easily obtained. One of the phenotypes that has been associated with pleiotropic mutations (single mutations affecting multiple functions) increasing the fungal enzyme production is the resistance to 2-deoxy-d-glucose (DG).14, 15 DG is a glucose toxic analog where the hydroxyl group at C-2 is replaced by a hydrogen atom. Once transported to the intracellular medium, DG is phosphorylated to DG-6-phosphate whose accumulation inhibits the cell growth.16, 17 In this way, when present in the medium, DG only allows resistant mutants to grow. Those mutants generally show catabolite repression resistance presenting increased enzyme production even when glucose is available.18 Mutants showing DG resistance have been isolated in different species of filamentous fungi.14, 18, 19, 20, 21, 22
In this context, the objective of this work was to investigate the deregulation of the catabolite repression in mutants of P. griseoroseum resistant to 2-deoxy-d-glucose. We were interested in mutants for industrial application specifically the ones that overproduce PL in a carbon source of lower cost as glucose.
The P. griseoroseum wild type strain, which was isolated from seeds of forest plants by Dr James J. Muchovej of the Departamento de Fitopatologia, Universidade Federal de Viçosa, Brazil, was used in two different strategies in order to isolate the DG-resistant mutants. Firstly, spontaneous mutants were isolated by plating 0.1 mL of a conidial suspension (107 conidia/mL) on agar minimum medium23 with 1% fructose and DG, testing the concentrations of 1, 2, 4 and 8 g/L. The plates were incubated at 25 °C for 7 days. This test allowed the determination of the minimum growth-inhibitory concentration of 2-deoxy-d-glucose in P. griseoroseum. The concentration of 4 and 8 g/L of DG completely inhibited the growth of the parental strain and all the further experiments were conducted with the concentration of 4 g/L. Secondly, UV irradiation was applied in a conidial suspension (107 conidia/mL) in order to isolate induced mutants. A conidial suspension (2 mL) on a Petri dish was exposed to UV light at a distance of 15 cm for 5 min to provide a survival rate of approximately 5%. Appropriate dilute conidial solution were plated on agar minimal medium with 4 g/L DG and 1% fructose and then incubated at 25 °C for 7 days. All the colonies (spontaneous or induced) showing DG-resistance were transferred to plates containing complete medium for conidial purification. Three mutants were instable and presented sectors (which are areas of the colony showing different morphological characteristics) that were also purified.
After purification, the pectinase production of the P. griseoroseum DG-resistant mutants and the three sectors was analyzed in solid medium by the diameter of the clear zone formed, caused by the pectin degradation around the discs containing part of the colony. For that, the mutants were transferred onto a medium containing (g/L): KH2PO4, 2.0; K2HPO4, 7.0; MgSO4·7H2O, 0.1; (NH4)2SO4, 1.0, pH 7.0, supplemented with 3.0 g citric pectin and 1.5 g agar. After 5 days of incubation at 25 °C, agar discs (7 mm diameter) containing mycelium from the colonies were transferred to MacIlvaine buffer (0.2 M Na2HPO4 and 0.1 M citric acid, pH 6.0), 0.25% citric pectin and 1.5% (w/v) agar and incubated for 48 h at 40 °C. Iodine–potassium iodine solution (1.0 g iodine, 5.0 g potassium iodine and 330 mL H2O) was added to detect clearing zones.
The PL activity on liquid medium was evaluated in mutants and sectors showing higher pectin degradation zones than the wild type. For that, the cultures were grown in a shaker (150 rpm) in Erlenmeyer flasks (125 mL) with 50 mL of a liquid medium (g/L): K2HPO4, 6.8; KH2PO4, 3.8; (NH4)2SO4, 1.0; MgSO4·7H2O, 1.1; yeast extract, 0.6, pH 6.3. The carbon sources were used: citrus pectin (Eskisa), 6.0 g/L; glucose, 6.0 g/L and glucose plus citrus pectin, 3.0 g/L each. To each flask 1 mL of a spore suspension of 5 × 107 was added and incubated at 25 °C for 120 h. That time represents the peak of PL production in P. griseoroseum.1 The pectin lyase activity was determined in the culture filtrates (supernatant) by measuring the increase in the absorbance at 235 nm as previously described by Albersheim and Killias24 with modifications. The reaction mixture was prepared with 1.5 mL of culture filtrate and 1 mL of 2.5% (w/v) citrus pectin (Sigma) in 50 mM phosphate buffer, pH 6.8, and incubated at 40 °C for 30 min. The reaction was stopped by the addition of 4.5 mL of 0.01 N HCl in 0.5 mL of reaction mixture. One unit of PL activity (U) was defined as one nmol of unsaturated products produced per mL culture filtrate per minute.
Nine UV-induced DG resistant mutants and three spontaneous mutants (named E01, E02 and E03) were obtained. During growth on solid medium, the mutants M03, M05 and M06 presented sectors (named M03′, M05′ and M06′) that were isolated and analyzed separately. The pectinases production in solid medium by the mutants and wild type revealed variations from 19.3 to 29.3 mm in diameter of the clear zone (Table 1). That represents −25.7% to +12.7% in relation to the degradation zone presented by the wild type. Although the color of the colony was not altered, some of the mutants showed growth and sporulation visually lower than the parental strain (Table 1). Poor sporulation, alteration in pigment formation and slight growth of DG-resistant mutants have also been reported by others.14, 21, 22, 25, 26 This is possibly resulted of common regulators being shared by both repression of conidiation and catabolite repression.27
Table 1.
Size of the enzyme degradation zone (mm) and morphological characteristics of Penicillium griseoroseum 2-deoxy-d-glucose resistant mutants.
| Strains | Pectin degradation | Colony color | Sporulation | Growth |
|---|---|---|---|---|
| WT | 26.0 | Green | + | + |
| E01 | 23.6 | Green | + | + |
| E02 | 25.0 | Green | + | + |
| E03 | 25.0 | Green | + | + |
| M01 | 22.4 | Green | + | + |
| M02 | 28.6 | Green | + | +/− |
| M03 | 28.0 | Green | + | + |
| M03′ | 28.3 | Green | + | +/− |
| M04 | 27.3 | Green | +/− | +/− |
| M05 | 29.3 | Green | + | +/− |
| M05′ | 29.0 | Green | + | +/− |
| M06 | 19.3 | Green | + | +/− |
| M06′ | 25.6 | Green | +/− | +/− |
| M07 | 27.6 | Green | +/− | + |
| M08 | 20.0 | Green | + | + |
| M09 | 21.6 | Green | +/− | +/− |
Strains with the letter “E” indicate spontaneous mutants and, with the letter “M”, the UV-induced ones.
M03′, M05′ and M06′ indicate purified sectors (colony areas with different morphology) of the mutants M03, M05 and M06.
Pectin degradation represents the diameter (mm) of the clear zone indicating pectinases activity.
(+) Sporulation and growth similar to the parental strain.
(+/−) Sporulation and growth lower than the parental strain.
The mutants (M02, M03, M04, M05 and M07) and the sectors (M03′ and M05′) were selected for PL production in liquid medium since they showed pectin degradation zones greater than the wild type. Those measurements were repeated three times, and the PL activity of most of the strains varied (from −12.0 to +94.4%) in all the repetitions (data not shown). In fact, after some transfers to nonselective medium, the selected mutants no longer showed resistance to DG, indicating an unstable phenotype. When obtained in P. purpurogenum, DG-resistant mutants also showed unstable cellulase activities.19 The only mutants presenting a stable DG resistance phenotype were the strains M03 and M04 (Fig. 1).
Fig. 1.
Growth of Penicillium griseoroseum 2-deoxy-d-glucose (DG) resistant mutants (M03 and M04) in agar minimal medium with 4 g/L DG and 1% fructose. WT indicates the wild type. The plate was incubated at 25 °C for 9 days.
The PL production of the P. griseoroseum wild type strain and the mutants M03 and M04 was evaluated in liquid medium containing three different carbon sources: pectin (0.6%), the natural inducer of pectinolytic enzymes; glucose (0.6%), which represses the production of pectinolytic enzymes; and a mix of both carbon sources (0.3% each). As expected, the higher PL production by the wild type was detected in the presence of pectin (Fig. 2). That pattern was not observed for M03 and M04. Both mutants showed resistance to catabolite repression presenting increased levels of PL in presence of glucose with or without pectin. Interestingly, PL activity was higher in the presence of pectin plus glucose, which is probably related to the amount of glucose used in the medium (3 g/L). It has been reported that a low concentration of glucose (bellow 5 g/L) is not enough to activate the catabolic repression.14, 28, 29 In fact, when pectin is mixed with a low concentration of glucose, not only the catabolite repression is not activated but there is also an increase in enzymatic activity.14, 28 Although our results corroborate these findings, it is not clear why mutants M03 and M04 produced higher amounts of PL when growing in pectin plus glucose. The mechanism associated to that response possibly involves both the lack of repression and induction of the plg1 expression. In our experiments, while the PL activity in pectin was similar for the wild type and M03, that mutant showed PL production 7.8-fold higher in glucose and 7.2-fold higher in glucose plus pectin when compared to the wild type (Fig. 2). Moreover, that mutant was consistent superior to M04 that showed PL production 31.1%, 38.4% and 33% lower in glucose, glucose plus pectin and pectin, respectively. In this way, besides being phenotypic stable, the mutant M03 showed higher resistance to catabolite repression.
Fig. 2.
Pectin lyase (PL) production by the 2-deoxy-d-glucose resistant mutants (M03 and M04) and the Penicillium griseoroseum wild type (WT). PL activity was measured in culture filtrates obtained after 120 h of growth in liquid medium containing different carbon sources (glucose 6%, glucose plus pectin 3% each, or pectin 6%). Unit of PL is defined as one nmol of unsaturated products produced per mL culture filtrate per minute.
In filamentous fungi, the catabolite repression usually inhibits the assimilation of more complex carbon sources if easier metabolized molecules are present. For this repression, CreA-like proteins bind to gene promoters containing the consensus sequence 5′-SYGGRG-3′ inhibiting the gene transcription.7 In P. griseoroseum, the deletion of CreA binding sites in the plg1 gene promoter abolished the catabolite repression by glucose.30 Assuming that mutations at the CreA binding sites do not lead to DG resistance in mutants M03 and M04, the difference in PL production between these mutants and the wild type should be associated to other genes. A number of mutations related to glucose assimilation are thought to confer DG resistance. In N. crassa and A. niger, as much as four loci are involved in DG resistance.18, 31 Defects in membrane transporters that would be less efficient in uptake DG, mutations in enzymes that promote DG phosphorylation and deficiencies in the phosphatase that hydrolyses DG preventing the accumulation of DG-6-phosphate, are the mechanisms though to be related to the DG resistance.16 For instance, the glucokinase gene from Escherichia coli is capable to restore the DG sensitivity in M. xanthus mutants. That suggests the loss of DG phosphorylation as the resistance mechanism that allowed the mutants to survive.25 The mechanism of glucose assimilation is not only involved with mutations leading to DG resistance but also with the cAMP signaling pathway because a correlation between glucose availability and the endogen cAMP level exists.32 Moreover, exogenous cAMP added to culture medium was capable of inducing PL in P. griseoroseum.8 In fact, modulators of cAMP (caffeine and sodium fluoride) induce the plg1 expression revealing that expression is dependent of the cAMP transduction signal.6 In this context, we hypothesized the mutation conferring DG resistance in mutants M03 and M04 could be related to the glucose assimilation that could increase the endogen level of cAMP culminating in a more effective PL production. Both mutants are interesting to be used in complementation studies in order to elucidate the putative mechanisms for DG resistance.
Increments in pectinase production by DG resistant mutants have been reported as much as 1.65-fold (138 U/g for the wild type versus 228 U/g by the mutant strain) in submerged fermentation.14 The 7.8-fold increase in PL production by mutant M03 is higher than that. It is also higher than the increase observed for others enzymes evaluated in DG-resistant mutants for other fungal species.20, 33 A 1.2-fold improvement in PL production has also been obtained by protoplast fusion between P. griseoroseum and P. expansum.12 Future attempts could evaluate the PL production after protoplast fusion between mutant M03 and other strain showing good PL production or between mutants M03 and M04. That strategy was used to increase the pectinase production in a diploid strain generated via parasexual recombination between two A. niger mutants previously reported as DG resistant and pectinase overproducing.31 Other strategy to increment PL production was reported by Cardoso et al.10 that obtained a 57-fold increase in PL production when a P. griseoroseum transformant, carrying the plg1 gene under control of a strong and constitutive promoter, was grown only in presence of glucose. In order to evaluate possible increment in PL production, that same strategy can be adopted but using the M03 mutant as recipient strain in the transformation experiments.
In conclusion, we have successfully demonstrated that 2-deoxy-d-glucose can be used for the isolation of catabolite repression resistant mutants in P. griseoroseum. For the first time, PL overproducing mutants in P. griseoroseum was reported. We suggested that the mutation leading to 2-DG resistance in the mutants could be related to the glucose assimilation that increases the endogenous cAMP level resulting in higher PL production. Mutant M03 is suitable to be evaluated in future experiments since it shows phenotypic stability and PL overproduction in medium containing glucose as sole carbon source. That is interesting because the use of glucose as carbon source could reduce PL production costs. Experiments in fermenter, after the optimization of culture conditions, can enlighten the usefulness of that mutant for industrial applications.
Conflict of interest
No authors have any conflicts of interest to declare.
Acknowledgements
The authors gratefully acknowledge the financial support of the Conselho Nacional de Desenvolvimento Científico e Tecnológico (CNPq), Financiadora de Estudos e Projetos (FINEP) and Fundação de Amparo à Pesquisa do Estado de Minas Gerais (FAPEMIG).
Associate Editor: Gisele Monteiro de Souza
References
- 1.Pereira J.F., Queiroz M.V., Gomes E.A., Muro-Abad J.I., Araújo E.F. Molecular characterization and evaluation of pectinase and cellulase production of Penicillium spp. Biotechnol Lett. 2002;24:831–838. [Google Scholar]
- 2.Jayani R.S., Saxena S., Gupta R. Microbial pectinolytic enzymes: a review. Process Biochem. 2005;40:2931–2944. [Google Scholar]
- 3.Alaña A., Gabilondo A., Hernando F. Pectin lyase production by Penicillium italicum strain. Appl Environ Microbiol. 1989;55:1612–1616. doi: 10.1128/aem.55.6.1612-1616.1989. [DOI] [PMC free article] [PubMed] [Google Scholar]
- 4.Yadav S., Yadav P.K., Yadav D., Yadav K.D.S. Pectin lyase: a review. Process Biochem. 2009;44:1–10. [Google Scholar]
- 5.Bazzolli D.S., Ribon A.O., Queiroz M.V., Araújo E.F. Molecular characterization and expression profile of pectin-lyase-encoding genes from Penicillium griseoroseum. Can J Microbiol. 2006;52:1070–1077. doi: 10.1139/w06-070. [DOI] [PubMed] [Google Scholar]
- 6.Bazzolli D.M.S., Ribon A.O.B., Reis K.C.P., Queiroz M.V., Araújo E.F. Differential expression of plg genes from Penicillium griseoroseum: plg1 a pectinolytic gene is expressed in sucrose and yeast extract. J Appl Microbiol. 2008;105:1595–1603. doi: 10.1111/j.1365-2672.2008.03905.x. [DOI] [PubMed] [Google Scholar]
- 7.Kiesenhofer D., Mach-Aigner A.R., Mach R.L. Understanding the mechanism of carbon catabolite repression to increase protein production in filamentous fungi. In: Schmoll M., Dattenböck C., editors. Gene Expression Systems in Fungi: Advancements and Applications. Springer International Publishing; 2016. pp. 275–288. [Google Scholar]
- 8.Baracat-Pereira M.C., Coelho J.L.C., Minussi R.C., Chaves-Alves V.M., Brandão R.L., Silva D.O. Cyclic AMP and low molecular weight effector(s) present in yeast extract are involved in pectin lyase production by Penicillium griseoroseum cultured on sucrose. Appl Biochem Biotechnol. 1999;76:129–141. doi: 10.1385/abab:76:2:129. [DOI] [PubMed] [Google Scholar]
- 9.Pereira J.F., Queiroz M.V., Lopes F.J.F., Rocha R.B., Daboussi M.J., Araújo E.F. Characterization, regulation, and phylogenetic analysis of the Penicillium griseoroseum nitrate reductase gene and its use as selection marker for homologous transformation. Can J Microbiol. 2004;50:891–900. doi: 10.1139/w04-081. [DOI] [PubMed] [Google Scholar]
- 10.Cardoso P.G., Ribeiro J.B., Teixeira J.A., Queiroz M.V., Araújo E.F. Overexpression of the plg1 gene encoding pectin lyase in Penicillium griseoroseum. J Ind Microbiol Biotechnol. 2008;35:159–166. doi: 10.1007/s10295-007-0277-6. [DOI] [PubMed] [Google Scholar]
- 11.Teixeira J.A., Gonçalves D.B., Queiroz M.V., Araújo E.F. Improved pectinase production in Penicillium griseoroseum recombinant strains. J Appl Microbiol. 2011;111:818–825. doi: 10.1111/j.1365-2672.2011.05099.x. [DOI] [PubMed] [Google Scholar]
- 12.Varavallo M.A., Queiroz M.V., Lana T.G., Brito A.R.T., Gonçalves D.B., Araújo E.F. Isolation of recombinant strains with enhanced pectinase production by protoplast fusion between Penicillium expansum and Penicillium griseoroseum. Braz J Microbiol. 2007;38:1–6. [Google Scholar]
- 13.Lara-Márquez A., Zavala-Páramo M.G., López-Romero E., Camacho H.C. Biotechnological potential of pectinolytic complexes of fungi. Biotechnol Lett. 2011;33:859–868. doi: 10.1007/s10529-011-0520-0. [DOI] [PubMed] [Google Scholar]
- 14.Antier P., Minjares A., Roussus A., Raimbault M., Viniegra-Gonzalez G. Pectinase-hyperproducing mutants of Aspergillus niger C28B25 for solid state fermentation of coffee pulp. Enzyme Microb Technol. 1993;15:254–260. [Google Scholar]
- 15.McCartney R.R., Chandrashekarappa D.G., Zhang B.B., Schmidt M.C. Genetic analysis of resistance and sensitivity to 2-deoxyglucose in Saccharomyces cerevisiae. Genetics. 2014;198:635–646. doi: 10.1534/genetics.114.169060. [DOI] [PMC free article] [PubMed] [Google Scholar]
- 16.Moore D. Effects of hexose analogues on fungi: mechanisms of inhibition and resistance. New Phytol. 1981;87:487–515. [Google Scholar]
- 17.Ralser M., Wamelink M.M., Struys E.A. A catabolic block does not sufficiently explain how 2-deoxy-d-glucose inhibits cell growth. Proc Natl Acad Sci USA. 2008;105:17807–17811. doi: 10.1073/pnas.0803090105. [DOI] [PMC free article] [PubMed] [Google Scholar]
- 18.Allen K.E., Mcnally M.T., Lowendorf H.S., Slayman C.W., Free S.J. Deoxyglucose-resistant mutants of Neurospora crassa: isolation, mapping, and biochemical characterization. J Bacteriol. 1989;171:53–58. doi: 10.1128/jb.171.1.53-58.1989. [DOI] [PMC free article] [PubMed] [Google Scholar]
- 19.Anwar M.N., Suto M., Tomita F. Isolation of mutants of Penicillium purpurogenum resistant to catabolic repression. Appl Microbiol Biotechnol. 1996;45:684–687. [Google Scholar]
- 20.Adsul M.G., Bastawde K.B., Varma A.J., Gokhale D.V. Strain improvement of Penicillium janthinellum NCIM 1171 for increased cellulase production. Bioresour Technol. 2007;98:1467–1473. doi: 10.1016/j.biortech.2006.02.036. [DOI] [PubMed] [Google Scholar]
- 21.Kumar P., Satyanarayana T. Overproduction of glucoamylase by a deregulated mutant of a thermophilic mould Thermomucor indicae-seudaticae. Appl Biochem Biotechnol. 2009;158:113–125. doi: 10.1007/s12010-008-8342-9. [DOI] [PubMed] [Google Scholar]
- 22.Mukherjee S., Chandrababunaidu M.M., Panda A., Khowala S., Tripathy S. Tricking Arthrinium malaysianum into producing industrially important enzymes under 2-deoxy-d-glucose treatment. Front Microbiol. 2016;7:596. doi: 10.3389/fmicb.2016.00596. [DOI] [PMC free article] [PubMed] [Google Scholar]
- 23.Pontecorvo G., Roper J.A., Hemmons L.M., MacDonald K.D., Bufton A.W.J. The genetics of Aspergillus nidulans. Adv Genet. 1953;5:141–238. doi: 10.1016/s0065-2660(08)60408-3. [DOI] [PubMed] [Google Scholar]
- 24.Albersheim P., Killias U. Studies relating to the purification and properties of pectin transeliminase. Arch Biochem Biophys. 1962;97:107–115. doi: 10.1016/0003-9861(62)90050-4. [DOI] [PubMed] [Google Scholar]
- 25.Youderian P., Lawes M.C., Creighton C., Cook J.C., Saier M.H. Mutations that confer resistance to 2-deoxyglucose reduce the specific activity of hexokinase from Myxococcus xanthus. J Bacteriol. 1999;181:2225–2235. doi: 10.1128/jb.181.7.2225-2235.1999. [DOI] [PMC free article] [PubMed] [Google Scholar]
- 26.Minjares-Carranco A., Trejo-Aguilar B.A., Aguilar G., Viniegra-González G. Physiological comparison between pectinase-producing mutants of Aspergillus niger adapted either to solid-state fermentation or submerged fermentation. Enzyme Microb Tech. 1997;21:25–31. [Google Scholar]
- 27.Ebbole D.J. Carbon catabolite repression of gene expression and conidiation in Neurospora crassa. Fungal Genet Biol. 1998;25:15–21. doi: 10.1006/fgbi.1998.1088. [DOI] [PubMed] [Google Scholar]
- 28.Fawole O.B., Odunfa S.A. Some factors affecting production of pectic enzymes by Aspergillus niger. Int Biodeter Biodegr. 2003;52:223–227. [Google Scholar]
- 29.Panda T., Nair S.R., Kumar M.P. Regulation of synthesis of the pectolytic enzymes of Aspergillus niger. Enzyme Microb Technol. 2004;34:466–473. [Google Scholar]
- 30.Bazzolli D.M.S., Reis K.C.P., Teixeira J.A., Ribon A.O.B., de Queiroz M.V., de Araújo E.F. The minimal regulatory region necessary for the expression of the Penicillium griseoroseum plg1 gene. Ann Microbiol. 2015;65:1145–1148. [Google Scholar]
- 31.Loera O., Aguirre J., Viniegra-González G. Pectinase production by a diploid construct from two Aspergillus niger overproducing mutants. Enzyme Microb Tech. 1999;25:103–108. [Google Scholar]
- 32.D'Souza C.A., Heitman J. Conserved cAMP signaling cascades regulate fungal development and virulence. FEMS Microbiol Rev. 2001;25:349–364. doi: 10.1111/j.1574-6976.2001.tb00582.x. [DOI] [PubMed] [Google Scholar]
- 33.Iwakuma H., Koyama Y., Miyachi A. Generation of a glucose de-repressed mutant of Trichoderma reesei using disparity mutagenesis. Biosci Biotechnol Biochem. 2015;80:486–492. doi: 10.1080/09168451.2015.1104236. [DOI] [PubMed] [Google Scholar]



